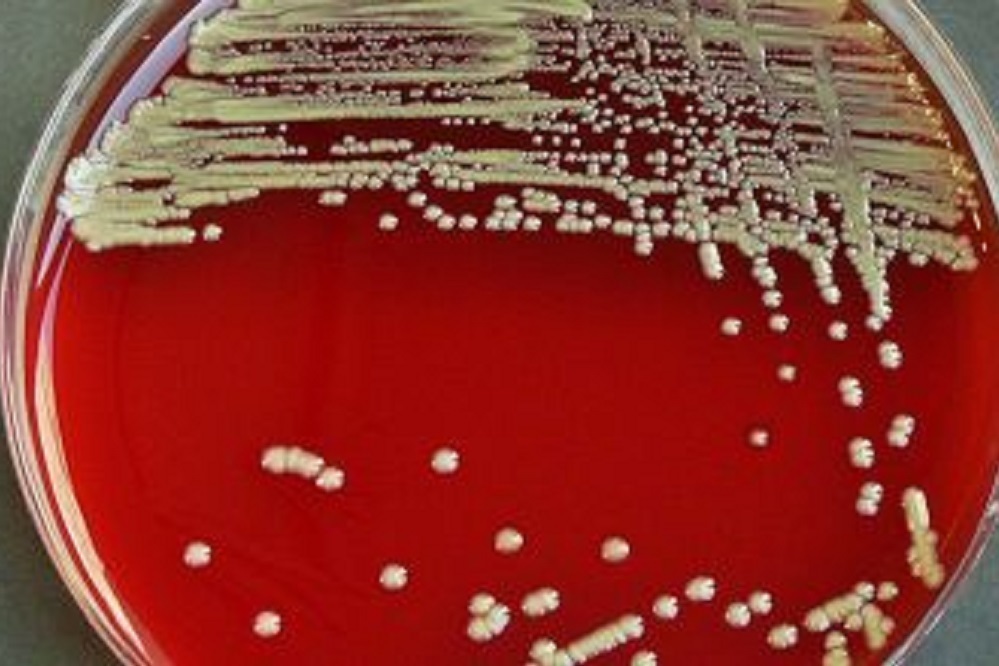

The U.S. Food and Drug Administration advises consumers and health care professionals to not use any liquid drug or dietary supplement products manufactured by PharmaTech LLC of Davie, Florida, and labeled by Rugby Laboratories, Major Pharmaceuticals and Leader Brands.
The FDA’s reason for the advice is that these products could potentially be contaminated with the bacteria Burkholderia cepacia (B. cepacia). There is a risk of severe patient infection.
“B. cepacia poses a serious threat to vulnerable patients, including infants and young children who still have developing immune systems,” FDA Commissioner Scott Gottlieb said in a statement. “These products were distributed nationwide to retailers, health care facilities, pharmacies and sold online – making it important that parents, patients and health care providers be made aware of the potential risk and immediately stop using these products.”
The Centers for Disease Control and Prevention note that B. cepacia is especially dangerous to hospitalized patients, critically ill patients and people with health problems.
PharmaTech makes drug and dietary supplement products such as liquid docusate sodium drugs (stool softeners), liquid vitamin D drops and liquid multivitamins marketed for infants and children.

Alerts Sign-up
Alerts Sign-up